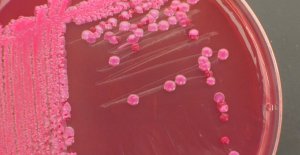

AGENCIJA ZA SIGURNOST HRANE BIH
U BiH nema slučajeva E. coli, ali se preporučuju m... U BiH nema hrane kontaminarane s Escherichia coli (E. coli) niti je bilo registriranih oboljelih, kazali su danas novinarima učesnici sastanka u Sarajevu koji je organizirala Agencija za sigurnost hrane BiH, u saradnji sa svim nadležnim institucijama države...
U BiH nema slučajeva E. coli, ali se preporučuju m... U BiH nema hrane kontaminarane s Escherichia coli (E. coli) niti je bilo registriranih oboljelih, kazali su danas novinarima učesnici sastanka u Sarajevu koji je organizirala Agencija za sigurnost hrane BiH, u saradnji sa svim nadležnim institucijama države...